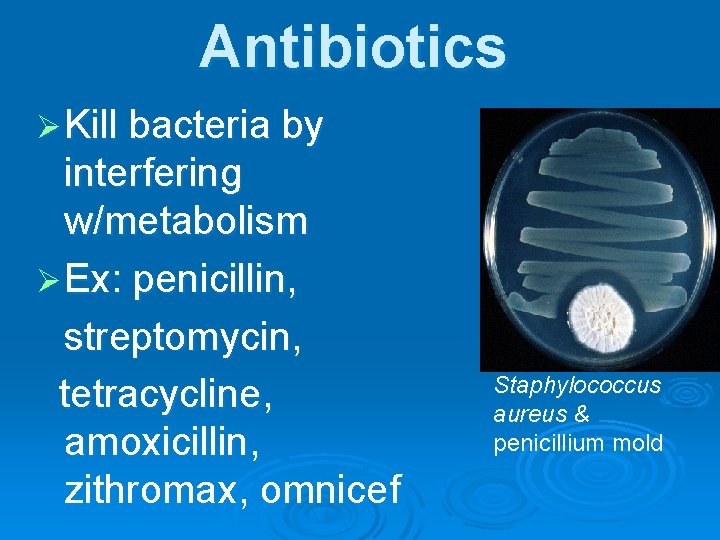
Antibiotics Ø Kill bacteria by interfering w/metabolism Ø Ex: penicillin, streptomycin, tetracycline, amoxicillin, zithromax,

Notes Bacteria General Characteristics Microscopic Exist everywhere Unicellular

Notes: Bacteria

General Characteristics Ø Microscopic, Exist everywhere Ø Unicellular Ø Prokaryotic (no nucleus or membrane bound organelles) E. coli is a typical bacterium that lives in the human intestines.

Kingdom Archaebacteria Found in extreme environments • Do not have peptidoglycan in cell walls • Instead have unique compounds in cell wall depending on species. Examples: 1. Methanogens - in oxygen-free environments, like animals’ intestines symbiosis 2. Halophiles – in concentrated saltwater 3. Thermoacidophiles – in hot, acidic waters of sulfur springs •

Kingdom Eubacteria Ecologically diverse • Have peptidoglycan in cell walls. Ø Heterotrophs l Decomposers l Parasites Ø Autotrophs • Cyanobacteria: common in ponds, streams, and moist areas of land.

General Bacteria picture Peptidoglycan Cell Wall Flagellum Cell membrane Ribosome DNA Pili

Basic Structure Ø No membrane-bound organelles Ø Small ribosomes Ø DNA - single circular chromosome Ø Cell wall (peptidoglycan) Ø Can be classified by shape & metabolism

Cell Shapes & Arrangements ØSpheres: cocci (-us) ØRods: bacilli (-us) ØSpiral: spirilla (-um) n. Pairs: Diplon. Cluster: Staphylon. Chain: Strepto-

Name this bacterium streptococcus

Metabolism Ø Obligate aerobes require oxygen for cellular respiration Ø Obligate anaerobes no oxygen, produce energy thru glycolysis/fermentation Ø Facultative anaerobes can survive with or w/out oxygen

Growth & Reproduction ØSome divide every 20 min. ØPop. held in check by food availability & wastes produced

1. Binary Fission Ø Asexual Ø Produces identical cells thru mitosis

2. Conjugation Ø Sexual Ø Exchange genetic info new gene combos & bacteria diversity

Endospore Ø Thick internal wall around DNA Ø Unfavorable growth conditions – heat, dry, no nutrients Ø Can remain dormant – years

Ecological Importance Ø Producers Ø Decomposers – recycle nutrients Ø Nitrogen fixers – ex. Soybeans Ø Sewage treatment

Human Importance Ø Foods: Swiss cheese, pickles, yogurt Ø Medicines: antibiotics Ø Crops: nitrogen fixation, control pests Ø Digestion: E. coli
Antibiotics Ø Kill bacteria by interfering w/metabolism Ø Ex: penicillin, streptomycin, tetracycline, amoxicillin, zithromax, omnicef Staphylococcus aureus & penicillium mold

How do bacteria make people sick? Ø 1. Produce toxins that “poison” host cells Ø 2. Bacterial cells crowd out healthy host cells.

Griffith’s Transformation Experiment Ø Pneumonia bacteria experiments Ø 1928 – Fredrick Griffith Ø Had isolated 2 strains of bacteria Smooth colonies – caused disease l Rough-edges colonies – no disease l

1

2

3

4

Summary of Griffith’s Transformation Mixing Rcells + heat-killed Scells causes a factor to transform the Rcells into Scells

Oswald Avery - 1944 Ø Extracted “juice” from heat-killed S bacteria + enzymes to destroy proteins, lipids, carbs, & RNA transformation still occurred Ø Extract + enzymes to destroy above & DNA NO transformation Ø DNA = Factor causing transformation

Diseases Ø Louis Pasteur Ø Few kinds release toxins or damage cells Ø Ex: tuberculosis, botulism, strep throat & scarlet fever, tetanus, pneumonia, anthrax, meningitis

Controlling Bacteria Ø Vaccines Ø Antibiotics Ø Sterilization Ø Disinfectants, Ø Food Processing & Storage
- Slides: 26